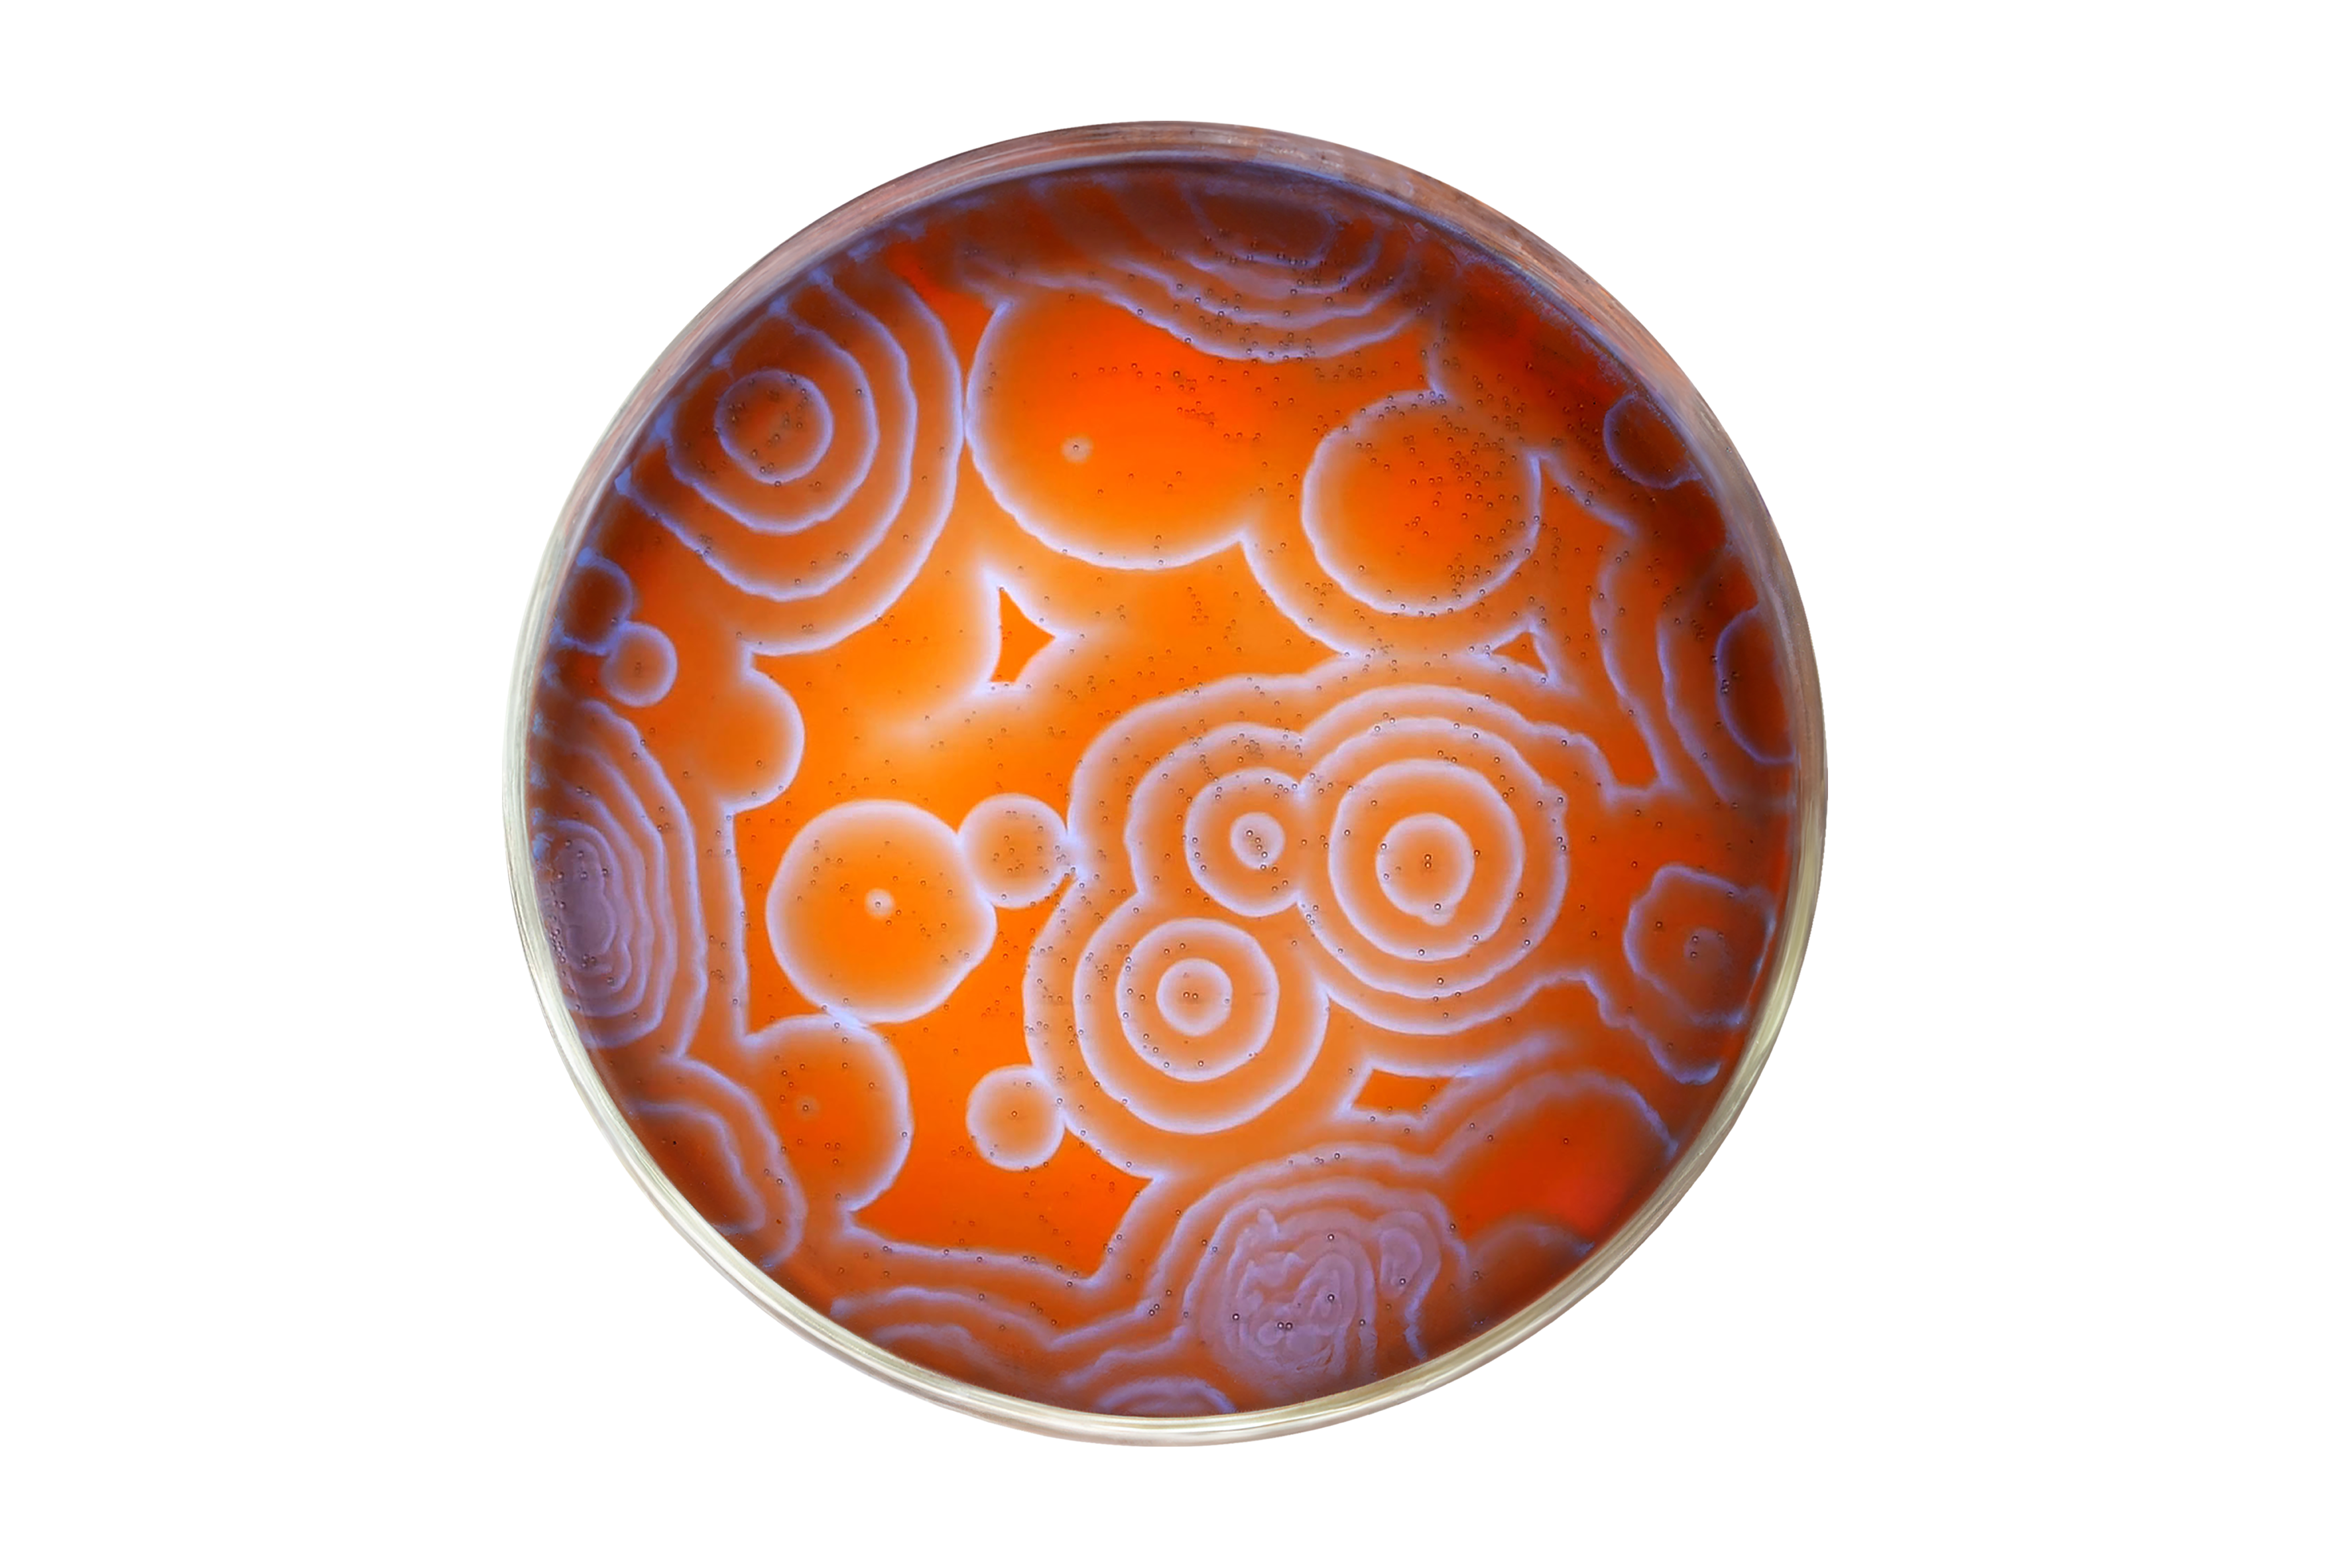

NileRed Classic Logo Shirt
$32.00
off
Item is in stock
Hurry! Low inventory
Item is out of stock
Item is unavailable
- Description
- Product Info
This classic shirt celebrates the first logo ever made for NileRed.
Printed on Bella + Canvas apparel
60% Cotton / 40% Poly
6 Month Return Policy
You may also like:
NileRed Beaker Mug
$25.00
Out of stockNileRed Classic Logo Shirt
$32.00
ABOUT THE CREATOR
NileRed
NileRed is a science creator dedicated to changing how chemistry is taught. By balancing theory with purpose, their goal is to capture the natural beauty of chemistry in fun and interesting ways.
- Related products
- Recently viewed
Invalid Password



